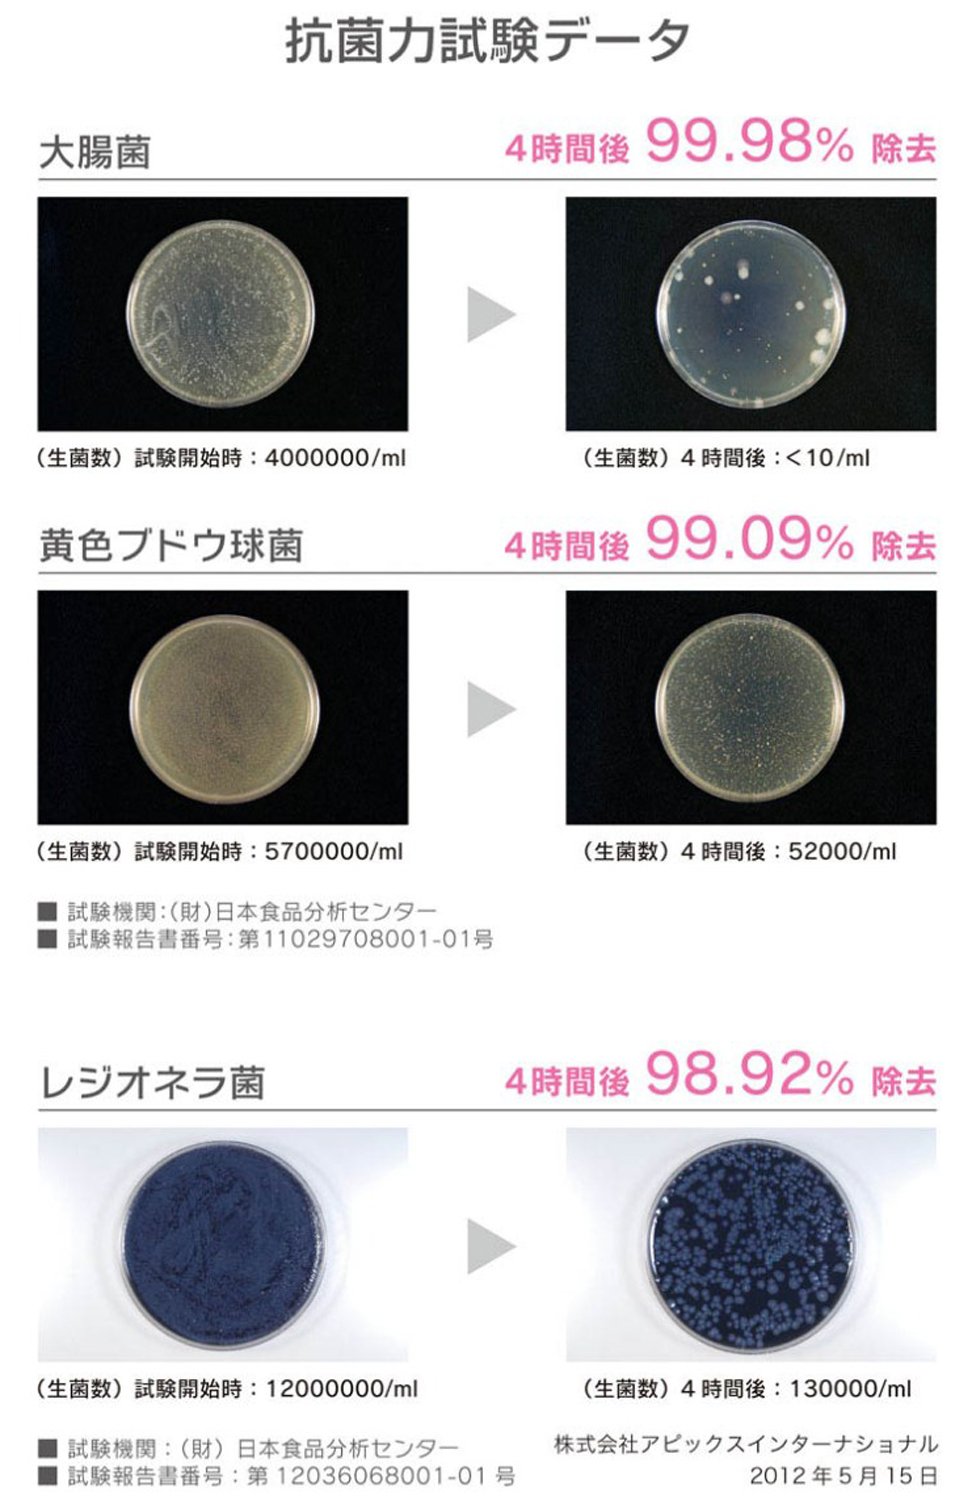

Item Descriptions:
color:
Floral pink
● Cute "drop type" humidifier mini size of adopted ultrasonic type steam is not hot.
A form like a drop arranges the interior beautifully.
Antibacterial cartridges, aroma oil compatible, LED lights, stepless humidification adjustment, etc. Humidifier full of functional aspects
● Antibacterial cartridge with suppression of bacterial growth.
Remove E. coli, Staphylococcus aureus, Legionella bacteria.
With a clean mist humidification of the room with confidence
● Personal type active on the desk or on the bedside.
Cute mini size design makes it one point of the room
● LED light directs a fantastic space.
A new function born from the voice of the customer saying "Brightness is anxious at bedtime ..." with on / off function of LED light!
Since you can turn on / off the LED, you can use it at will when you go to bed
● Adjustable steam humidity
● Blowout port 360 ° rotation
● With aroma tray.
You can enjoy your favorite scent while humidifying (※ Note 1) Aroma oil sold separately (※ Note 2) Use aromatic tray without putting aroma oil in water.
Putting aromatic oil in water will cause product failure
● Electricity cost per hour is about 0.54 yen (tax included) * Calculated at 1 kw / h = 27 yen (tax included)
Features:
Product information:
Shipping Weight: 1065 g
Package Dimensions: 19.00 x 19.20 x 29.01 cm
SHIPPING METHOD
Delivered directly from Japan by Japan Post. It will take 3 to 5 business days to prepare the order for shipping. We guarantee careful packing and safe shipping.Please note that in some cases additional import or VAT charges may incur and have to be borne by the client.
1. Japanpost registered mail
Shipment by Japanpost Registered Mail (Standard). Trackable any time with tracking number. Insurance is not available. Delivery time usually is between 1-3 weeks from the date of dispatch. Some items are not eligible for Standard Shipping.
2. Qxpress Standard
Shipment by Qxpress standard service. Trackable at any time with tracking number. Registered and insured up to a value of item price and shipping fees.Delivery time is usually between 5-10 business days from the date of dispatch.
3. EMS
Shipment by Expedited Mail Service. Trackable at any time with tracking number. Registered and insured up to a value of $200 and usually delivered in 2-6 business day from the date of dispatch.

| Japanpost registered mail | Qexpress | EMS | |
|---|---|---|---|
| Shipping Method | Japanpost Registered Mail (Standard) | Standard Qexpress | EMS (Expedited Mail Service) |
| Trackable | Yes | Yes | Yes |
| Insured | N/A | Yes (Up to item price and shipping fees) | Yes (Up to $200.00) |
| Asia | 1-3 weeks | 5-10 days | 2-5 days |
| Oceania; North America; Central America and the Middle East | 2-4 weeks | 6-14 days | 2-6 days |
| Europe | 2-4 weeks | 6-16 days | 3-8 days |
| South America and Africa | 2-4 weeks | 10-18 days | 4-8 days |
NOTICE:
"According to Qoo10 guide line,overseas shipping fees will be charged to you extra if you choose Qxpress standard shipping.We recommend you to compare the total price of your purchase with EMS."
